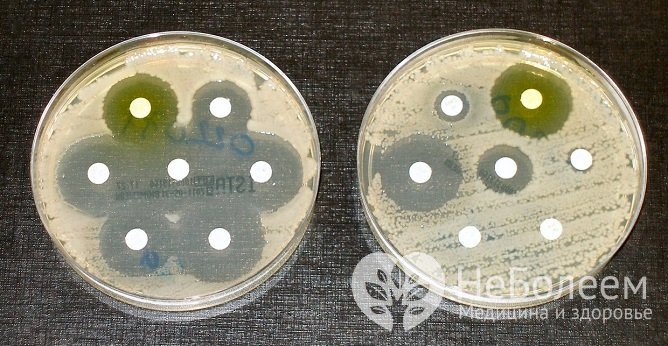
В ходе бактериологического анализа определяется чувствительность микроорганизмов к антибиотикам

Воспользуйтесь поиском по сайту:
Как сдать мочу на бакпосев
Содержание статьи:
Как сдать мочу на бакпосев – один из часто задаваемых вопросов. Это связано с тем, что многие факторы способны исказить результат анализа. Для получения достоверных данных важно ответственно подойти к подготовке и выполнять все рекомендации.
Бактериологическое исследование мочи (бакпосев) – вид лабораторного анализа, который назначают для определения инфекционных агентов, вызывающих воспалительные заболевания почек и мочевыводящих путей, а также для определения эффективности лечения инфекции.
 Мочу для бакпосева собирают в пластиковый одноразовый стерильный контейнер
Мочу для бакпосева собирают в пластиковый одноразовый стерильный контейнерСреди микроорганизмов, которые могут стать причиной воспалительных заболеваний мочевыделительной системы, большое значение имеет условно-патогенная флора, то есть бактерии, которые присутствуют и в здоровом организме, но могут становиться патогенными и активно размножаться при определенных условиях. Поэтому определить видовой состав микрофлоры мало – нужно оценить и изменения ее количественного состава. Для этого проводят бактериологическое исследование материала, в ходе которого определяется не только вид бактерий, выделяющихся с мочой, но и их концентрация. Кроме того, анализ позволяет провести тест на чувствительность патогенных микроорганизмов к антибиотикам.
Способствовать развитию инфекции может ослабление иммунитета, гормональные нарушения, переохлаждение, длительная антибактериальная терапия, несоблюдение правил личной гигиены, стресс.
До бактериологического посева во многих лабораториях проводится первичная микроскопия – исследование осадка мочи, иногда позволяющее сразу идентифицировать возбудителя. Но для более подробного изучения и достоверного результата всегда необходим бактериологический анализ.
Как проводится бакпосев
Образец осадка мочи помещается на питательные среды, которые обеспечивают благоприятные условия для роста микробных колоний. Такой питательной средой может служить кровяной агар, сахарный бульон и другие растворы, разным возбудителям подходят разные среды. Чаще всего в лаборатории производится посев на несколько питательных сред. Главный критерий оценки патогенности микробов – их способность расти и размножаться, то есть образовывать колонии, поэтому концентрация бактерий в определенном объеме мочи определяется не количеством отдельных бактерий, а числом колониеобразующих единиц – КОЕ. Под колониеобразующей единицей подразумевается бактериальная клетка, из которой при посеве вырастает видимая колония микроорганизмов.
Если при посеве обнаруживают высокое количество бактерий (104 и более КОЕ/мл), проводится тест на антибиотикочувствительность. Он позволяет определить, какие антибактериальные средства наиболее эффективно останавливают рост колоний.
Показания для бакпосева
Бактериологический посев назначает врач-терапевт, инфекционист, гинеколог или педиатр. Показаниями служат воспалительные заболевания мочевыводящих путей и почек:
Основанием для бактериологического исследования мочи могут быть следующие симптомы:
- жжение, боль при мочеиспускании;
- учащение позывов к мочеиспусканию;
- выделения из мочеиспускательного канала;
- изменение цвета мочи;
- изменения в общем анализе мочи;
- нарушения половой функции.
Набирать материал для исследования можно в любое время суток после 2-3 часов задержки мочеиспускания, но лучше всего использовать первую утреннюю мочу.
Кроме того, бакпосев назначается при беременности даже тем женщинам, у которых отсутствуют любые симптомы и неприятные ощущения с целью выявления бессимптомной бактериурии.
Как сдать мочу на бакпосев
Посев должен проводиться до начала лекарственной терапии. Исключение составляют случаи, когда анализ проводится для оценки эффективности такого лечения.
Нужно заранее позаботиться о емкости, в которой образец будет доставлен в лабораторию. Она должна быть стерильной, без следов моющих или дезинфицирующих средств. Лучше всего использовать специальные стерильные контейнеры для анализов, которые продаются в аптеке или выдаются в лаборатории при записи на исследование.
В ходе бактериологического анализа определяется чувствительность микроорганизмов к антибиотикам
В ходе бактериологического анализа определяется чувствительность микроорганизмов к антибиотикамНабирать материал для исследования можно в любое время суток после 2-3 часов задержки мочеиспускания, но лучше всего использовать первую утреннюю мочу, концентрация бактерий в ней будет максимальной. Перед тем, как собирать мочу для исследования, важно провести тщательный туалет половых органов, чтобы материал не был загрязнен бактериями, содержащимися в выделениях. По этой же причине нельзя прикасаться контейнером к коже. Для бакпосева обычно используют среднюю порцию мочи. Чтобы правильно ее собрать, первую порцию струи нужно спустить в унитаз, после этого подставить контейнер и набрать 100–150 мл.
Материал нужно быстро доставить в лабораторию, иначе результат может быть недостоверным. Если это невозможно, собранную мочу следует хранить в холодильнике. Максимальный срок хранения материала – 2 часа.
Главный критерий оценки патогенности микробов – их способность образовывать колонии, поэтому концентрация бактерий в определенном объеме мочи определяется не количеством отдельных бактерий, а числом колониеобразующих единиц – КОЕ.
Читайте также:Как избежать цистита: 7 правил поведения для женщин
Расшифровка результатов анализа
В ходе исследования могут быть обнаружены следующие бактерии:
- стафилококки и стрептококки – проникают в мочу через уретру или через кровь от инфицированных очагов. Типичные симптомы инфицирования: слабость, лихорадка, головные боли, высыпания, диарея, тошнота, жжение в процессе мочеиспускания, зуд в половых органах, увеличение лимфоузлов, ангина, хронический тонзиллит;
- синегнойная палочка – в урологии является причиной развития пиелонефритов, циститов, уретритов. Ее присутствие в мочеполовых путях сопровождается следующими признаками: повышенная температура, частое болезненное мочеиспускание, неприятный запах мочи, изменение ее цвета, пенистость, боли в пояснице. Хроническая инфекция может быть бессимптомной и выявиться только в ходе анализа мочи;
- кишечная палочка – провоцируют воспаление органов мочеполовой системы и почек. Превышение нормальных показателей ее содержания в моче может означать наличие инфекционных процессов в урогенитальной сфере (цистит, пиелонефрит, аднексит, эндометрит, везикулит, уретрит, простатит, орхит, кольпит). Симптомы инфекционно-воспалительного процесса: режущие боли при мочеиспускании, лихорадка, неприятный запах мочи, слизь, белые хлопья или кровяные разводы в урине, слизистые сгустки, боли в животе, диарея;
- протейная инфекция – может поражать желудочно-кишечный тракт, мочеполовую систему, заражать послеоперационные раны и места ожогов. Основные симптомами заражения: повышение температуры, диарея, метеоризм, урчание в кишечнике, рвота, кратковременные судороги;
- клебсиелла – активно размножается в организме, выделяя токсические вещества, в результате чего начинается воспаление в легких, кишечнике, мочевыводящих путях (цистит, пиелонефрит, простатит, уретрит, кольпит). Устойчива к большинству антибиотиков. Возможны осложнения тяжелой инфекции в виде сепсиса, инфекционно-токсического шока, геморрагического синдрома.
Среди микроорганизмов, которые могут стать причиной воспалительных заболеваний мочевыделительной системы, большое значение имеет условно-патогенная флора.
Способствовать развитию инфекции может ослабление иммунитета, гормональные нарушения, переохлаждение, длительная антибактериальная терапия, несоблюдение правил личной гигиены, стресс. Признаки инфицирования организма зависят от вида возбудителя и места его обитания.
Бактериурия, не превышающая 103 КОЕ/мл мочи, свидетельствует об отрицательном результате анализа, в данном случае микроорганизмы рассматриваются как результат контаминации мочи. Бактериурия, равная 104 КОЕ/мл мочи, расценивается как сомнительный результат (исследование нужно повторить). Бактериурия выше 105 КОЕ/мл указывает на бактериальное инфицирование.
Видео с YouTube по теме статьи:
Об авторе

Нашли ошибку в тексте? Выделите ее и нажмите Ctrl + Enter.
В Великобритании есть закон, согласно которому хирург может отказаться делать пациенту операцию, если он курит или имеет избыточный вес. Человек должен отказаться от вредных привычек, и тогда, возможно, ему не потребуется оперативное вмешательство.
























